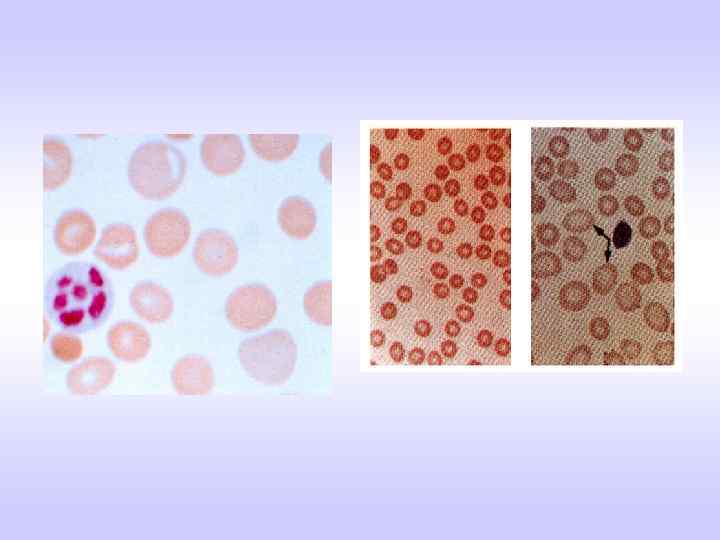

Анем-2.май11берем.ppt
- Количество слайдов: 68

Диагностика и лечение анемии у беременных Проф. Т. З. Сейсембеков, АО «Медицинский университет Астана»

Впервые выявленная заболеваемость ЖДА в РК за 2004 -2008 г. г. Годы 2004 2005 2006 2007 2008 2009 РК 1388, 5 1532, 7 2182, 4 2095, 6 2062, 0 2044, 6 (100%) (>47, 2%) 710, 3 872, 9 1368, 6 1036, 0 980, 0 935, 1 (100%) (>31, 6%) Акм. обл. Кар. обл. СКО 1059, 7 1463, 3 1465, 3 1328, 6 1180, 8 1189, 7 (100%) (>12, 3%) 963, 7 1613, 0 1713, 0 1572, 3 1432, 4 1298, 2 (100%) (> 34, 7%)

Темы основных НИР Кар. ГМА и Акм. ГМА 1. Научно-методические и организационные основы диспансеризации студентов (ГР № 01860012216) 2. Медико-экологические проблемы здоровья населения Центрального Казахстана» (ГР № 01910001433) 3. Изучение основных закономерностей влияния факторов окружающей среды на здоровье и структуру заболеваемости различных контингентов населения, усовершенствование методов лечения и профилактики заболеваний в регионе Cеверного Казахстана (ГР № 01910011712)

Дизайн исследования Исследования проводилсь в г. г. Караганда, Темиртау и Астана в 4 -х сельских районах Карагандинской и 8 -ми - Акмолинской обл. Всего первичным скрининговым исследованием были охвачены более 16 тыс. студентов 5 -ти вузов г. Караганды и около 15 тыс. взрослого городского и сельского населения указанных территорий. Углубленное обследование проведено около 6 тыс. студентам и более 8 тысяч взрослого населения. Больных ЖДА всего 1718 чел Методики исследования Анкетирование (анкета для раннего выявления железодефицитной анемии и дефицита железа, разработанная в ВГНЦ МЗ СССР и модифицированная нами с учетом этнических и экологических особенностей наших регионов). Проведение общепринятых лабораторно-биохимических исследований, а также специальные лабораторные (клеточного и гуморального иммунитета, перекисного окисления липидов и антиоксидантной защиты, гемореологических свойств эритроцитов и пр. ) Электро- и психофизиологические (ЭКГ, анализ сердечного ритма и пр. ) Ультразвуковые, рентгено-радиологические и др. Показатели обмена железа: сывороточное железо (СЖ), общая железосвязывающая способность сыворотки (ОЖСС), коэффициент насыщения трансферина железом (КНТ), сывороточный ферритин (СФ). Лечение: Препараты железа: сорбифер дурулес, гемофер, лечение проводилось в течение 3 -х месяцев по схеме полного насыщения; + аскорбиновая кислота в дозе 0, 2 г 3 раза в день, фитосбор из листьев крапивы, “пастушьей сумки”, “мать и мачехи” и пр.

Критерии отбора и группы наблюдения по данным анкетирования Группы наблюдения Критерии отбора Практически здоровые лица Отсутствие положительных ответов на вопросы анкеты; Нв >120 г/ л(девушки), >130 г/ л (юноши). Группа «малого» риска по дефициту железа Наличие 1 -2 положительных ответов в анкете; Нв> 120 г / л (дев. ), > 130 г/ л (юн. ) Группа «высокого» риска по дефициту железа Наличие 3 и более положительных ответов в анкете; Нв < 120 г/ л(дев. ), < 130 г/ л (юн. ).

Показатели красной крови у здоровых юношей и девушек Юноши (п = 309) Девушки (п = 1162) Эритроциты (х 1012 л) 4, 69 0, 02 (4, 24 – 5, 14) 4, 32 0, 01 (3, 80 – 4, 80) Гемоглобин (г/л) 150, 1 0, 41 (132, 2 - 168, 0) 131, 8 0, 28 (116, 0 - 147, 6) Среднее содержание 31, 94 0, 15 Нв в эритроцитах (27, 59 - 36, 29) 30, 70 0, 10 (27, 04 - 34, 35)

Критерии диагноза ДЖ и ЖДА Диагноз дефицита железа (ДЖ) без анемии выставлялся при наличии хотя одного из критериев: - снижение СЖ менее 12, 5 мкмоль/л; повышения уровня ОЖСС более 64, 4 мкмоль/л и уменьшения значения КНТ ниже 16%. Такой же диагноз был правомочен, вне зависимости от вышеуказанных критериев, при снижении концентрации СФ менее 20 мкг/л и нормальных значениях гемоглобина; Диагноз железодефицитной анемии (ЖДА) выставлялся на основании характерной клиники, наличия гипохромной анемии, снижения СЖ ниже 12, 5 мкмоль/л; повышения уровня ОЖСС более 64, 4 мкмоль/л и уменьшения значения КНТ ниже 16%, а также снижение СФ менее 12 мкг/л Степень тяжести анемии оценивали по рекомендациям ВОЗ (1973); Митерева Ю. Г. , Альперина П. И. (1983): - I ст. - легкая, при гемоглобине (Нв) от 118 до 90 г/л; - II ст. – средняя, при Нв от 89 до 70 г/л; - III ст. - тяжелая, при Нв менее 70 г/л.

Анемии у беременных • • Анемиями называют патологические состояния, при которых отмечается снижение гемоглобина и/ или количества эритроцитов в единице объема крови вследствие: кровопотерь нарушенного образования эритроцитов ускоренного разрушения эритроцитов сочетания вышеуказанных причин

Физиологическая гемодилюция при беременности • При беременности происходит увеличение массы плазмы на 60% и эритроцитов на 20%, то есть наблюдается физиологическая гиперволемия (гемодилюция). • Допустимыми пределами физиологической гемодилюции при беременности считаются: • Снижение гемоглобина до 100 -110 г/л • Эритроцитов до 3, 6 х 109 /л • В отличие от истинной анемии при физиологической гемодилюции нет морфологических изменений эритроцитов

Физиологическая гемодилюция при беременности • Клинически протекает бессимптомно • Лечения не требует • С окончанием беременности в течение 1 -2 недель восстанавливается нормальная картина крови

ЖДА у беременных • Железодефицитные анемии (ЖДА) развиваются у 40% беременных и составляют 90% всех анемий у беременных. • ЖДА развивается в основном за счет увеличения потребности в Fe, особенно при повторных беременностях (интервал менее 3 лет), многоплодии, гестозах. • Невосполнимая потеря железа при каждой беременности ~ 700 мг. Обеднение депо на 50%.

Анемии у беременных(эпидемиология) - По данным ВОЗ - 600 млн. человек страдает ЖДА. Наиболее часто ЖДА встречается у женщин детородного возраста, беременных и детей различных возрастных групп. - В Европе и в России у 10 -12% женщин детородного возраста развивается ЖДА - Наряду с истинной ЖДА существует скрытый дефицит железа, который в Европе и России составляет 30%, а в некоторых регионах (Север, Сев. Кавказ, Восточная Сибирь) - 50 -60%, в Японии-70%

Анемии у беременных(эпидемиология) • По данным ВОЗ, частота ЖДА среди беременных колеблется от 14% в странах Европы до 70% в Юго. Восточной Азии. • В целом число беременных с ЖДА достигает 43, 9 млн. , или 51% от общего числа беременных (Ежегодный отчет ВОЗ, Женева, 2002). • По данным Минздрава РФ, несмотря на огромный выбор на фармацевтическом рынке ферропрепаратов (многокомпонентных и комбинированных), частота железодефицитных анемий (ЖДА) у беременных за последнее десятилетие возросла в 6, 3 раза, и только в Москве она составляет 38, 9%

Железодефицитные анемии • Дефицит железа является одним из распространенных микроэлементозов человека • Около 1/3 – 1/5 женщин репродуктивного возраста имеют низкий запас депонированного железа и у 10% имеется манифестная ЖДА • ЖДА - состояние, обусловленное снижением содержания железа в сыворотке крови, костном мозге и депо в связи с его потерей или повышенной потребностью. • В результате этого нарушается образование гемоглобина, возникают гипохромная анемия и трофические расстройства в тканях.

Обмен железа в норме • С пищей ежедневно поступает 15 -20 гр. железа. • В 12 -перстной кишке и проксимальных отделах тощей кишки в обычных условиях всасывается 1 -1, 5 мг, при повышенной потребности организма в железе – 2 -3 мг. • Железо пищи – на ионы Fe ++ и Fe+++ • В желудке Fe ++ переходит в Fe+++ • Трансферрин доставляет в клетки • Восстановление Fe ++ и синтез гема • Часть Fe+++ в виде ферритина – запасы «функциональное» • Основная часть железа находится в гемоглобине – 65 %, • В тканевых ферментах -0, 5%. • Миоглобин- 3, 5 % • «транспортное» железо - в плазме – траснферрин- 0, 1%,

Обмен железа в норме • • • мышцы (ферритин) – 3, 5 %, печень, селезенка, гол. мозг (ферритин, гемосидерин)– 31% Ферритин - сохраняет запасы железа Гемосидерин – производное ферритина В организме взрослого человека содержится 3 -4 г железа Для продукции новых эритроцитов ежедневно расходуется 25 мг железа. • Теряется около 1 мг (с калом, с потом, желчью, мочой) • Основной расход железа наблюдается во время менструального цикла, беременности и лактации. При беременности и лактации теряется 800 -900 мг железа. После беременности, родов и лактации гемоглобин восстанавливается через 4 -5 лет • При обильных менструациях выделяется 50 -250 мг железа.

Влияние различных веществ на всасывание железа Усиливающие Аскорбиновая кислота Фруктоза, сорбит Янтарная кислота Тормозящие Танины чая Антациды Энтеросорбенты Алкоголь Карбонаты, оксалаты, фосфаты Лимонная, яблочная, винная Молоко кислоты Апельсиновый сок Растительные волокна, отруби Животные белки(рыба, мясо) Аминокислоты Жиры Фитаты

Потребность в Fe во время беременности • I триместр - 2 мг/сутки. • II триместр - 2 -3 мг/сутки. • III триместр - 3 -5 мг/сутки. • Особенно возрастает потребность в Fe с 1620 недель беременности, когда начинается костномозговое кроветворение плода и увеличивается масса крови в материнском организме. Если до беременности был скрытый дефицит Fe, то к 20 неделе беременности - истинная ЖДА.

Потребность в Fe во время беременности: • Во время беременности 300 -500 мг Fe используется для выработки дополнительного Hb, • 25 -50 мг - на построение плаценты, • 250 -300 мг - мобилизуется на нужды плода, • Около 50 мг - откладывается в миометрии, • 100 -150 мг теряется во время родов, • 250 -300 мг - во время лактации за 6 мес. Прекращение менструации не компенсирует этих потерь.

Дополнительные потери железа у женщин • . Менструация – 30 -60 мл (15 -30 мг) Менструация • Беременность – 500 мг (ребенку300 мг. , в плаценту- 200 мг) • В родах – 50 - 100 мг • Лактация – 400 - 700 мг

Этиология ЖДА • Неполноценная диета • Нарушение всасывания железа • Хронические потери крови из различных органов и тканей • Повышенная потребность в железе (беременность, лактация, интенсивный рост) • Внутрисосудистый гемолиз • Комбинация этих причин

Хронические потери крови – наиболее важная причина ЖДА • Желудочно-кишечные кровотечения (геморрой, прием салицилатов, язвенная болезнь желудка и двенадцатиперстной кишки, дивертикулез, опухоли, НЯК, полипоз кишечника) • Мено-метроррагии • Геморрагические диатезы • Донорство • Гематурический нефрит, МКБ • Синдром Гудпасчера

Нарушение всасывания • Тотальная гастрэктомия • Резекция желудка по Бильрот 2 ( «конец в бок» ), когда происходит выключение части 12 -перстной кишки • Ваготомия с гастрэктомией • Спру, хронические энтериты, энтеропатии • Ферментопатии • Обширная резекция тонкого кишечника

Неполноценное питание • • Вегетарианство Голодание Употребление крепкого чая, кофе Приготовление пищи на жесткой воде Дефицит витамина С Гипопротеинемии различного генеза (нарушение транспорта железа)

Патогенез ЖДА Дисбаланс между потребностями и поступлением железа в организм ( более 2 мг/сут) 1. Прелатентный дефицит железа -первоначально уменьшаются запасы железа в печени, селезенке, костном мозге (снижение ферритина в крови) без уменьшения концентраци сывороточного железа Происходит компенсаторное усиление всасывания железа в кишечнике 2. Латентный дефицит железа – характеризуется истощением железа в депо; несмотря на сохраняющийся высокий уровень трансферрина в крови, значительно снижается содержание железа в крови. 3. Железодефицитная анемия- характеризуется снижением синтеза гемоглобина, снижением насыщения трансферрина железом, повышением общей железосвязывающей способности сыворотки.

Клиника ЖДА Анемический синдром • слабость, повышенная утомляемость • бледность кожи и видимых слизистых оболочек • сердцебиение, одышка при физических нагрузках Сидеропенический синдром • поперечная исчерченность, ломкость ногтей, койлонихии • извращение вкуса (желание есть мел, песок, глину, острую, соленую пищу) • сглаженность сосочков языка, «заеды в углах рта • пристрастие к необычным запахам ( бензина, лака для ногтей, ацетона, горелых спичек, нафталина)



Клиника ЖДА • • • Разрушение эмали зубов и развитие кариеса Задержка физического и умственного развития Снижение памяти Развитие иммунодефицита Развитие эндокринных нарушений Сидеропеническая дисфагия , развитие атрофического гастрита и энтерита • Симптом «синих склер» (за счет нарушения гидроксилирования пролина и лизина, а затем синтеза коллагена, склера истончается и через нее просвечивает сосудистая оболочка глаза) • Императивные позывы на мочеиспускание, невозможность удержать мочу при смехе, кашле, чихании, ночное недержание мочи за счет слабости сфинктеров мочевого пузыря • Снижение репаративных процессов в коже и слизистых оболочках

Диагностика ЖДА • Снижение гемоглобина менее 100 г/л • Низкий цветовой показатель (менее 0, 85) • Снижение среднего содержания гемоглобина в эритроцитах • Гипохромия эритроцитов (центр. просветление и периф. окрашивание в соотношении 2: 1, 3: 1) • Микроцитоз • Анизоцитоз- неодинаковая величина эритроцитов • Пойкилоцитоз- различная форма эритроцитов • Снижение сывороточного железа (менее 12, 5 мкмоль/л) • Насыщение трансферрина железом – менее 25 % • Повышение общей железосвязывающей способности сыворотки (более 70, 0 мкмоль/л) • Снижение сывороточного ферритина (менее 12 мкг/л)

Определение причин и источника кровопотери • Гинекологическое обследование, УЗИ гениталий. • ЭФГДС, колоноскопия, ректороманоскопия, реакция Грегерсена • Общий анализ мочи, проба Нечипоренко, Зимницкого. УЗИ почек, мочевого пузыря. Цистоскопия. • Исследование мочи на БК. • Определение гемосидерина в мокроте, бронхоскопия, анализ промывных вод бронхов на БК, исследование мокроты на атипические клетки. • ЛОР-обследование • Подсчет количества тромбоцитов • Исследование адгезии и агрегации тромбоцитов • Коагулограмма

Основные осложнения беременности при ЖДА • Плацентарная недостаточность (18 -24%) и связанные с ней хроническая гипоксия и синдром задержки внутриутробного развития плода, • Угроза невынашивания и преждевременных родов (1142%) • Гестоз (40 -50%), преимущественно отечнопротеинурической формы • Дефицит железа и недостаточное его депонирование в антенатальном периоде приводят к росту перинатальной заболеваемости, развитию ЖДА у новорожденных. • Нарушение сократительной активности матки (10 -15%) • Несвоевременное излитие околоплодных вод (8 -10%) • Гипотонические кровотечения (7 -8%) • Гнойно-воспалительные осложнения (эндометрит - 12%, мастит - 2%), гипогалактия (до 38%)

Группа высокого риска по развитию ЖДА • Женщины с анемией, гиперполименореей в анамнезе, • Многорожавшие; • Имеющие острые или рецидивирующие хронические инфекционные заболевания (печени, почек и т. д. ); • Многоводием; гестозом и др.

Рекомендации ВОЗ при беременности • Все беременные с І триместра (не позднее 10 -11 -й нед. гестации) и до родов должны получать 60 мг элементарного железа и 400 мкг фолиевой кислоты в сутки. • При выявлении у беременной ЖДА суточная доза препаратов увеличивается в 2 раза.

Рекомендации ВОЗ/ЮНИСЕФ (1995) Вторичная профилактика при ЖДА легкой и средней степени • Еженедельная доза для всех беременных женщин – 400 мг сульфата железа(120 мг элементарного железа) и 0, 5 мг фолиевой кислоты • Еженедельная доза для небеременных женщин в возрасте 15 -49 лет – 200 мг сульфата железа (60 мг элементарного железа) и 0, 25 мг фолиевой кислоты.

Принципы ведения беременных с ЖДА 1) Раннее выявление беременных группы высокого риска по развитию анемии. К ним относят беременных с анемией в анамнезе, наличием инфекционных, сердечно-сосудистых, онкологических и других заболеваний, болезнями крови и желудочно-кишечного тракта, многорожавшие, с многоплодием, осложнениями в период настоящей беременности (ранний токсикоз, гестоз, др. ), аутоиммунными нарушениями и др. ; 2) Тщательное обследование пациенток на наличие ЖДА и выявление ее причин; 3) Своевременная профилактика или лечение ЖДА с использованием специальной диеты и современных медикаментозных средств, подобранных индивидуально, с учетом феррокинетических показателей.

Основные принципы медикаментозной терапии ЖДА • Диета • Выбор наиболее эффективного препарата • Выбор максимально переносимой дозы

Диета при ЖДА • Наилучшим источником биологически доступного железа являются мясо. Из мяса – говядина и телятина (всасывается 22%) т. к. железо в виде гема; рыба (всасывается 11%) , т. к. железо в виде гемосидерина и ферритина • Употребление чая снижает усвоение железа из продуктов смешанного завтрака на 50%. Сеанс чаепития должен начинаться не ранее, чем через 30 минут после приема основной пищи. • Тепловая обработка снижает уровень железа в продуктах питания от 5 до 25%. • В процессе длительного хранения, глубокого замораживания продукты теряют от 15 до 51% содержащегося железа. • Аскорбиновая кислота способствует восстановлению трехвалентного железа и переходу его в более усвояемую двухвалентную форму • Приучите своих пациентов к употреблению сырых овощей.

Рекомендации ВОЗ по ведению беременных с ЖДА • Назначают пероральные препараты (удобны в применении, хорошо переносятся) с содержанием Fe(+2) и наличием сульфата железа - Fe. SO 4 (лучше абсорбируются, эффективны, дешевле), с замедленным выделением Fe(+2) (лучше абсорбция и переносимость). • Необходимая суточная доза для профилактики анемии и лечения легкой формы заболевания составляет 50 -60 мг Fe(+2), • С анемией ІІ и ІІІ степени - 100 -120 мг Fe(+2).

Показания для парентеральной ферротерапии • Нарушения всасывания • Язвенная болезнь желудка и 12 перстной кишки в стадии обострения • Непереносимость препаратов железа для приема внутрь

Космофер- низкомолекулярный декстран железа (III) • • Получен методом особой фракционной перегонки Приближен к физиологическому железу ферритина Имеет низкую молекулярную массу 150 000 дальтон Железо, крепко сцепленное с декстраном, теряет свою токсичность Запатентован в США и Западной Европе Является альтернативой гемотрансфузиям Эффективен при необходимости быстрого транспорта железа в его депо (предстоящие роды, предоперационная подготовка) Токсикозы беременных

Космофер (Дания) 1 ампула = 100 мг Fe(III)/ 2 мл повышает уровень гемоглобина на 15 -30 ед. Внутримышечно без разведения 1 раз в неделю. Внутривенно, капельно , медленно– на 100 мл физ. раствора или 5% раствора глюкозы 2 -3 раза в неделю. При необходимости быстрого транспорта железа общая доза препарата должна составлять 20 мг/кг массы тела пациентки Обязательно проведение тест-дозы: - при в/м введении – 0, 5 мл препарата в/м - При в/в капельном введен первые 25 мг препарата течение 20 мин. , затем оставшуюся дозу в течение 1 часа Курсовая доза подбирается индивидуально в зависимости от исходного уровня гемоглобина и массы тела

Феркайл (Бельгия) • Высокая безопасность и клиническая эффективность • Одновременно повышает уровень гемоглобина в крови и депонируется в печени и селезенке • Европейское качество • Высокая терапевтическая эффективность: 1 ампула повышает уровень гемоглобина на 7 единиц • Хороший комплаенс: обычная дозировка 1 раз в день • Не требует стимуляторов всасывания • Не требует дополнительного курса на замещение • Только внутримышечно без разведения 1 раз в день. Вводить глубоко внутримышечно методом складки • Разовая доза – 2 мл • Обязательно проведение тест-дозы- 0, 5 мл. • Курсовая доза подбирается индивидуально в зависимости от исходного уровня гемоглобина и массы тела

Витамин В-12 -дефицитная анемия Это заболевание, обусловленное истощением запасов витамина В-12 в организме, что влечет за собой нарушение синтеза ДНК в клетках.

Этиология В-12 ДА • Нарушение всасывания (атрофический гастрит, глютеновая энтеропатия, обширная резекция тонкой кишки, хронический панкреатит) • Нарушение поступления (вегетарианство) • Конкурентное поглощение (инвазия широким лентецом, дисбактериоз кишечника, слепые петли после резекции кишечника) • Нарушение транспорта (гипопротеинемия, цирроз печени) • Образование аутоантител к париетальным клеткам слизистой оболочки желудка, внутреннему фактору Кастля

Патогенез В-12 ДА • Витамин В-12 является кофактором, необходимым для образования тетрагидрофолиевой кислоты из фолиевой кислоты. • Активная тетрагидрофолиевая кислота участвует в синтезе пуиновых и пиримидиновых оснований нуклеиновых кислот, т. е. в синтезе ДНК. • Дефицит витамина В-12 приводит к нарушению синтеза ДНК, что лежит в основе изменения нормального гемопоэза. • Изменения гемопоэза затрагивают все клеточные линии • В клетках блокируется синтез ДНК, что приводит к нарушению процесса деления клеточного ядра и преждевременной гибели гемопоэтических предшественников в костном мозге (неэффективный эритропоэз). • Нарушение реакции превращения метилмалонового кофермента А в сукцинил-кофермент. А при участии аденозилкобаламина. • Накопление метилмалоновой кислоты, нарушение синтеза жирных кислот приводит к развитию фуникулярного миелоза. • При дефиците витамина В-12 нарушается синтез миелина и происходит демиелинизация периферических нервных волокон.

Клиническая картина В-12 ДА • Анемический синдром с лимонно-желтым оттенком • Глоссит (боли во рту или языке) • Фуникулярный миелоз – нарушение чувствительности, ощущение ползания мурашек, онемения конечностей, ваты под ногами, легкие болевые ощущения в кончиках пальцев • Незначительное увеличение селезенки

Диагностика В-12 ДА • • Гиперхромная, макроцитарная анемия Тельца Жолли, кольца Кебота Умеренная лейкопения, тромбоцитопения Правый сдвиг, наличие гиперсегментированных (5 сегментов) нейтрофилов. • В миелограмме- мегалобластное кроветворение, раздраженный красный росток (соотношение миелоидного и эритроидного ростка 1: 3), большое количество мегалобластов, отсутствие оксифильных форм, костный мозг- базофильный ( «синий костный мозг» )

Лечение В-12 ДА Цианкобаламин • 1000 мкг 1 раз в сут в/м или в/в(1 неделю) • 1000 мкг 2 раза в неделю в/м или в/в(1 неделю) • 1000 мкг 1 раз в неделю в/м (4 недели) • 1000 мкг 2 раза в месяц в/м (6 месяцев) • 1000 мкг 1 раз в месяц в/м (пожизненно) Оксикобаламин • 500 -1000 мкг ежедневно или через день • При развитии неврологической симптоматики- 1000 мкг каждые 2 недели в течение 6 месяцев

Лечение В-12 ДА • Контролировать уровень калия в плазме • При развитии гипокалиемии показана заместительная терапия • Гемотрансфузии – при прекоматозном или коматозном состоянии по 250 -300 мл (до начала ведения витамина В-12) Профилактика В-12 ДА • У больных с резецированным желудком- 500 мкг № 12 - 1 раз в год или по 500 мкг -1 раз в месяц. • При невозможности устранения причины больные нуждаются в пожизненной терапии.

Фолиеводефицитная анемия Заболевание, обусловленное истощением запасов фолиевой кислоты в организме, следствием чего является нарушение синтеза ДНК.

Этиология ФДА • Увеличение потребности во время беременности, лактации, у пациентом с хроническим гемолизом и миелопролиферативными заболеваниями. • Недостаточное поступление с пищей (апельсины, шпинат, зеленые овощи, рис, печень, спаржа и др. ) • Постоянный прием противосудорожных препаратов, антагонистов фолиевой кислоты (метотрексат, 6 -меркаптопурин, оральных контрацептивов). • Алкоголизм • Синдром мальабсорбции • Наследственный дефицит ферментов

Патогенез ФДА • Фолиевая кислота участвует в синтезе дезокси-тимидин-фосфата из дезокси-уридин -монофосфата. Данная реакция необходима для обеспечения нормального синтеза ДНК в клетке. • Дефицит фолиевой кислоты приводит к развитию мегалобластного кроветворения в костном мозге и развитию гиперхромной макроцитарной анемии.

Клиника и диагностика ФДА • • Гиперхромная макроцитарная анемия Легкая иктеричность склер Редко – глоссит Нет признаков фуникулярного миелоза Нормальное или низкое количество ретикулоцитов Отсутствие изменений гранулоцитов и тромбоцитов. Мегалобластное кроветворение в костном мозге Снижение содержания фолиевой кислоты в эритроцитах (норма- 100 -450 нг/л)

Лечение ФДА • Фолиевая кислота – 5 -15 мг/сут до нормализации гемоглобина • Обогащение пищевого рациона фолатами • Профилактическая доза – 1 -5 мг/сут.

Гемолитические анемии Это патологические состояния, развивающиеся вследствие повышенного разрушения эритроцитов и характеризующиеся укорочением продолжительности жизни красных кровяных телец. Наследственный сфероцитоз ( Минковского. Шоффара) • Аутосомно-доминантное наследование • Дефицит белков мембраны эртроцитов (спектрина, анкирина)

Патогенез • При дефиците спектрина происходит потеря липидов в мембране эритроцитов • Внутрь эритроцитов поступает большое количество ионов натрия • Накопление воды внутри эритроцитов, изменение двояковогнутой формы на сферическую • Нарушение способности эритроцитов изменять форму при прохождении через сосуды микроциркуляторного русла • Отщепление части поверхности эритроцитов в сосудах селезенки, разрушение микросфероцитов макрофагами селезенки

Клиника и диагностика наследственного микросфероцитоза • Стигмы дисэмбриогенеза( башенный череп, готическое небо, изменение расположения зубов, микроофтальмия, укорочение мизинцев) • Желтуха лимонно-желтой окраски • Спленомегалия • Желчнокаменная болезнь( в 50%) • Нормохромная анемия • Ретикулоцитоз • Микросфероцитоз (диаметр эритроцитов менее 6 мкм) • Гиперплазия клеток эритроидного ряда • Непрямая гипербилирубинемия • Снижение осмотической стойкости эритроцитов • Отрицательная проба Кумбса

Лечение наследственного микросфероцитоза • Спленэктомия – в 1 -м триместре или после родов • Фолиевая кислота – 5 мг/ сут. • Вопрос о холецистэктомии решается исходя из клинической ситуации • Гемотрансфузии – при глубокой анемизации.

Иммунные гемолитические анемии • Изоиммунные- воздействие экзогенных антител к антигенам эритроцитов больного • Трансиммунные- связаны с воздействием антител, проникающих через плаценту и направленных против антигенов эритроцитов ребенка • Гетероиммунные (гаптеновые)- развивающиеся в результате фиксации на поверхности эритроцита нового экзогенного антигена-гаптена (лекарства, вирусы) • Аутоиммунные- возникающие в результате обазования аутоантител против антигенов собственных эритроцитов.

Патогенез иммунных гемолитических анемий • Классификация антител по механизму действия(агглютинины, гемолизины, преципитины); по температурному оптимуму активности(тепловые, холодовые); по серологической характеристике(полные, неполные).

Клиника и диагностика АИГА • • Анемический синдром Желтуха лимонно-желтого оттенка Спленомегалия (при внутриклеточном гемолизе) Выделение мочи цвета «пива» , темно-коричневая окраска кала Боли в пояснице, боли в животе, выделение мочи черного цвета, тромбозы – при внутрисосудистом гемолизе Нормохромная анемия с ретикулоцитозом Положительная прямая и непрямая проба Кумбса Наличие свободного гемоглобина в плазме, гемосидерина в моче (при внутрисосудистом гемолизе)

Лечение АИГА • Преднизолон- 1 -2 мг/кг массы тела внутрь в течение 4 -6 -недель, далее постепенное снижение по 5 мг в нед. В критических ситуациях – пульс- терапия метилпреднизолоном – 1000 мг/сут в течение 3 -х дней. Показания к спленэктомии: • Неэффективность преднизолона • Зависимость от преднизолона в дозе 20 мг/сут и более • Ранний рецидив после отмены преднизолона • Препараты 3 -й линии- иммунодепрессанты (циклоспорин А, имуран). При беременности – противопоказаны. • Мабтера (Ритуксимаб)- 375 мг/м 2 1 раз в неделю № 4.

Профилактика ЖДА у беременных • Профилактика требуется беременным с высоким риском развития анемии -восполнение запасов тканевого железа, уменьшая риск развития ЖДА при повторных беременностях. Заместительная терапия железом способствует повышению массы плода при рождении. • Профилактические меры у беременных заключаются в назначении небольших доз железосодержащих препаратов (1 -2 таблетки в день), начиная с 12 -14 -й нед. беременности. • Лечение проводится курсами по 2 -3 нед. с перерывами 2 -3 нед. ; всего 3 -4 курса.

Медицинские показания к искусственному прерыванию беременности (Приказ МЗ РК № 626 от 30. 10. 09 г. ) 2. Новообразования: наличие в настоящем или прошлом злокачественных новообразований всех локализаций. 4. Болезни крови и кроветворных органов: 1) апластическая анемия; 2) часто рецидивирующие или тяжело протекающие пурпура и другие геморрагические состояния.

Спасибо за внимание ВСЕМ ЖЕЛАЕМ СЧАСТЬЯ
Анем-2.май11берем.ppt